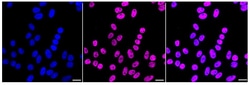
Invitrogen U2AF2 Recombinant Rabbit Monoclonal Antibody (24GB2465) 100

missing translation for 'onlineSavingsMsg'
Learn More
Learn More
Invitrogen™ U2AF2 Recombinant Rabbit Monoclonal Antibody (24GB2465)


Rabbit Recombinant Monoclonal Antibody
Brand: Invitrogen™ MA557810
This item is not returnable.
View return policy
Description
U2AF2 Recombinant Monoclonal Antibody for Western Blot, ICC/IF, Flow
U2 auxiliary factor (U2AF), comprised of a large and a small subunit, is a non-snRNP protein required for the binding of U2 snRNP to the pre-mRNA branch site. This gene encodes the U2AF large subunit which contains a sequence-specific RNA-binding region with 3 RNA recognition motifs and an Arg/Ser-rich domain necessary for splicing. The large subunit binds to the polypyrimidine tract of introns early during spliceosome assembly. Multiple transcript variants have been detected for this gene, but the full-length natures of only two have been determined to date.
Specifications
| U2AF2 | |
| Recombinant Monoclonal | |
| Unconjugated | |
| U2AF2 | |
| 65kDa; hU2AF(65); hU2AF65; splicing factor U2AF 65 kDa subunit; U2 (RNU2) small nuclear RNA auxiliary factor 2; U2 auxiliary factor 65 kDa subunit; U2 small nuclear ribonucleoprotein auxiliary factor (65kD); U2 small nuclear ribonucleoprotein auxiliary factor (U2AF) 2; U2 small nuclear ribonucleoprotein auxiliary factor (U2AF), 65 kDa; U2 small nuclear RNA auxiliary factor 2; U2 snRNP auxiliary factor large subunit; U2AF2; U2af65; Unknown (protein for MGC:137461) | |
| Rabbit | |
| Affinity Chromatography | |
| RUO | |
| 11338, 22185, 308335 | |
| -20°C | |
| Liquid |
| Flow Cytometry, Western Blot, Immunocytochemistry | |
| 24GB2465 | |
| PBS with 50% glycerol and 0.02% sodium azide; pH 7.4 | |
| P26368, P26369 | |
| U2AF2 | |
| A synthesized peptide derived from human U2AF65 (aa 415-475). | |
| 100 μL | |
| Primary | |
| Human, Mouse, Rat | |
| Antibody | |
| IgG |
Product Content Correction
Your input is important to us. Please complete this form to provide feedback related to the content on this product.
Product Title
Spot an opportunity for improvement?Share a Content Correction